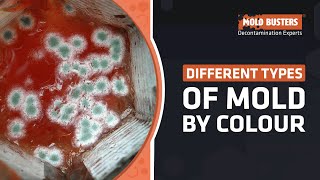
Different Types of Mold by Colour - Mold Busters

Table of Contents:
Welcome to the ultimate music portal! If you have been desperately looking for the Red Colored Mold Mp3 Download (2.66 MB) MP3, this is exactly where you need to be. There is nothing quite like finding that perfect song to match your mood. Our platform offers everything you must know and the best approach to get the audio file directly to your device.
The Story Behind Red Colored Mold Mp3 Download (2.66 MB)
Listening to Red Colored Mold Mp3 Download (2.66 MB) is a must for any music lover. The combination of beautiful melodies, rhythmic vibes, and deep lyrics makes it a true gem. It has gained traction on social media, and fans worldwide are trying to figure out how to enjoy it offline.
Why We Love Red Colored Mold Mp3 Download (2.66 MB) So Special
Have you wondered why Red Colored Mold Mp3 Download (2.66 MB) has taken the internet by storm. The secret is its amazing sound and the captivating energy that leaves a lasting impact. Perfect for relaxing, studying, or working out, this track delivers the best vibes.
Red Colored Mold Mp3 Download (2.66 MB) Gallery
Free Download Guide for Red Colored Mold Mp3 Download (2.66 MB) Audio
We know that listening online requires a stable connection, so saving the Red Colored Mold Mp3 Download (2.66 MB) MP3 is the best option. Here is a comprehensive collection of the original versions and the top remixes. Follow the simple steps, follow the straightforward steps, and securely save the crisp audio file to your device for offline listening.
To Sum It Up
Finally, listening to Red Colored Mold Mp3 Download (2.66 MB) can make your day better. Hopefully, this guide helped you find the music you love. Disclaimer: We do not host these files on our servers, they are for promotional use. Please remember to support the original artists by streaming their songs on official platforms such as official channels.